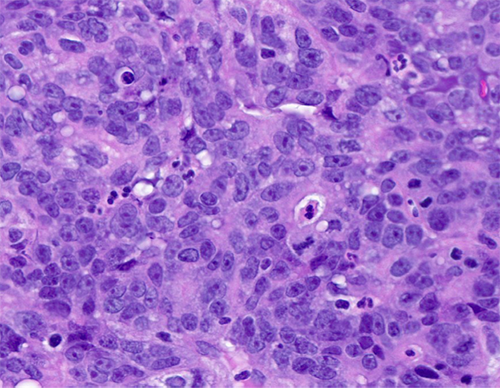

January 2024 Case
Authors
Subramanya Sakaleshpura Mallikarjunappa, MD (Fellow), Danielle Hutchings, MD (Faculty)
Gastrointestinal Pathology
Clinical History
A patient in his 60’s with a clinical history of presumed metastatic pancreatic cancer presented with jaundice, weakness, decreased appetite and vomiting.
Patient's symptoms started 3 months ago with fatigue, poor appetite, epigastric abdominal pain and >50lbs weight loss over 3 months. Additionally, there were episodes of dark urine, watery diarrhea and diplopia. Physical examination was notable for scleral icterus and pitting edema. Endoscopy showed severe fungating and ulcerated intraluminal masses diffusely involving the entire stomach suspicious for gastric cancer which was biopsied.
Diagnosis
Poorly differentiated carcinoma, Epstein-Barr virus (EBV)-associated.
Discussion
In this case, the histology showed sheets of poorly differentiated neoplastic cells with admixed predominantly neutrophilic inflammation. The neoplastic cells were positive for cytokeratins AE1/AE3 and CAM 5.2 consistent with carcinoma. They were diffusely positive for EBV by in-situ hybridization. DPC4/SMAD4, which shows loss of expression in approximately half of pancreatic ductal adenocarcinomas, showed retained expression. Immunohistochemical stains for mismatch repair proteins (MLH1, PMS2, MSH2, and MSH6) showed retained nuclear protein expression in the neoplastic cells. Immunohistochemistry for Her-2 was negative (score 0) and PD-L1 showed a combined positive score (CPS) of 5.
Approximately 10% of primary gastric carcinomas are associated with EBV, whereas EBV-associated pancreatic carcinomas are exceedingly rare, limited to only a handful of reported cases in the literature (1, 2). In this case, the endoscopic impression of diffuse involvement of the stomach and association with EBV strongly favor a primary gastric carcinoma despite the patient's reported clinical history of pancreatic cancer. DPC4/SMAD4 was retained by immunohistochemistry and is non-contributory; however, it should be noted that a proportion of EBV-associated gastric cancers may show pathogenic alterations in DPC4/SMAD4, and thus loss would not have been specific for pancreatic origin in this case (3). Moreover, none of the published cases of EBV-associated pancreatic cancer included information on DPC4/SMAD4 status by immunohistochemistry or molecular methods.
EBV was first identified in association with lymphoepithelial carcinoma of the stomach by Burke et. al. in 1990 (4). EBV-associated gastric carcinomas are often poorly-differentiated, consisting of irregular sheets, trabeculae, ill-defined tubules, or syncytia, and show prominent associated lymphocytic inflammation which may be intra- and/or peritumoral. In the 2019 World Health Organization (WHO) classification of digestive tumors, tumors with this morphology are categorized within the morphologic subtype of gastric carcinoma with lymphoid stroma (6). However, the morphologic spectrum EBV-associated carcinoma is variable and they may also show conventional tubular/intestinal adenocarcinoma morphology (5,7). Interestingly, our case showed intratumoral inflammatory cells, but they were predominantly neutrophils rather than lymphocytes. Positivity for EBV is typically established by in-situ hybridization by detection of positive signals within tumor cells.
EBV-associated tumors are more common in men and often present at a younger age. They are frequently located in the proximal stomach or gastric remnant after prior gastrectomy (6,7). Characteristic molecular changes in EBV associated gastric cancers include DNA hypermethylation, frequent pathogenic alterations in PIK3CA and ARID1A, and overexpression of JAK2 and PD-L1/L2 (7). Identification of EBV-associated gastric carcinomas is important as they have better prognosis with lower frequency of lymph node metastasis and may potentially be amenable to more conservative therapies, such as endoscopic resection. Moreover, they represent a promising candidate for treatment with immune checkpoint inhibitor therapy for patients with advanced disease (5,7).
References
- Murphy G, Pfeiffer R, Camargo MC, Rabkin CS. Meta-analysis shows that prevalence of Epstein-Barr virus-positive gastric cancer differs based on sex and anatomic location. Gastroenterology. 2009 Sep;137(3):824-33. doi: 10.1053/j.gastro.2009.05.001. Epub 2009 May 13. Erratum in: Gastroenterology. 2011 Mar;140(3):1109. PMID: 19445939; PMCID: PMC3513767.
- Samdani RT, Hechtman JF, O'Reilly E, DeMatteo R, Sigel CS. EBV-associated lymphoepithelioma-like carcinoma of the pancreas: Case report with targeted sequencing analysis. Pancreatology. 2015 May-Jun;15(3):302-4. doi: 10.1016/j.pan.2015.03.016. Epub 2015 Apr 9. PMID: 25922198; PMCID: PMC5029421.
- He CY, Qiu MZ, Yang XH, Zhou DL, Ma JJ, Long YK, Ye ZL, Xu BH, Zhao Q, Jin Y, Lu SX, Wang ZQ, Guan WL, Zhao BW, Zhou ZW, Shao JY, Xu RH. Classification of gastric cancer by EBV status combined with molecular profiling predicts patient prognosis. Clin Transl Med. 2020 Jan;10(1):353-362. doi: 10.1002/ctm2.32. PMID: 32508039; PMCID: PMC7240851.
- Burke AP, Yen TS, Shekitka KM, Sobin LH. Lymphoepithelial carcinoma of the stomach with Epstein-Barr virus demonstrated by polymerase chain reaction. Mod Pathol. 1990 May;3(3):377-80. PMID: 2163534.
- Fukayama M, Abe H, Kunita A, Shinozaki-Ushiku A, Matsusaka K, Ushiku T, Kaneda A. Thirty years of Epstein-Barr virus-associated gastric carcinoma. Virchows Arch. 2020 Mar;476(3):353-365. doi: 10.1007/s00428-019-02724-4. Epub 2019 Dec 13. PMID: 31836926.
- World Health Organization. Classification of tumors [as of 2/18/2024]. Digestive System Tumours. Available from https://tumourclassification.iarc.who.int/chaptercontent/31/29.
- Yang J, Liu Z, Zeng B, Hu G, Gan R. Epstein-Barr virus-associated gastric cancer: A distinct subtype. Cancer Lett. 2020 Dec 28;495:191-199. doi: 10.1016/j.canlet.2020.09.019. Epub 2020 Sep 23. PMID: 32979463.

Figure 1 - Low power view: Gastric mucosa infiltrated by sheets of poorly differentiated malignant cells.

Figure 2 - High power view: Sheets of poorly differentiated malignant cells with admixed inflammatory cells (predominantly neutrophils).
Figure 3 - The neoplastic cells show amphophilic cytoplasm, nuclear enlargement, hyperchromasia, prominent nucleoli. Patchy neutrophilic infiltrate seen.

Figure 4 - The neoplastic cells were diffusely positive for cytokeratin AE1/AE3.

Figure 5 - The malignant cells were diffusely positive for EBV by in-situ hybridization.